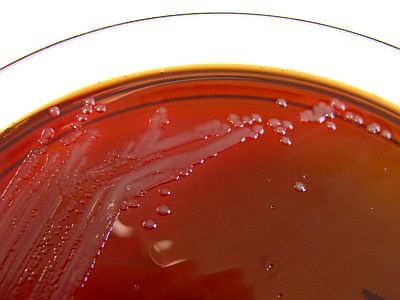
Neisseria meningitidis

Magyar Sebkezelő Társaság


Meningococcus és sebkezelés
Várhegyi László2024. április 11.
0 hozzászólás
Az USA egészségügyi hatósága felhívta az orvosok figyelmét, hogy az országban egyre több esetben fordul elő az olyan ritka, középkorú felnőtteket érintő meningococcus-fertőzés, amely és magasabb halálozási arányt mutat a szokásosnál – vette át a CNN hírét április 2-án a Penzcentrum.hu. A Neisseria meningitidis baktérium által okozott fertőzés meningitist (agy- és gerincvelőgyulladást) és vérmérgezést okozhat. Tipikus tünetei: láz, fejfájás, merev nyak, fényérzékenység és hányinger. Azonban sok mostani eset eltér ezektől a szimptómáktól, például kétharmaduknál véráramfertőzés (láz, hidegrázás, sötétlila kiütés) volt megfigyelhető. Vajon van-e a baktériumnak vagy a meningococcusnak kapcsolódása a sebkezeléshez? – erre keresem a választ a mostani blogbejegyzésben.
 Az emberek 5-25%-a hordozza a N. meningitidis baktériumot az orr és a torok hátsó részén anélkül, hogy bármilyen betegséget vagy tünetet mutatna. Amennyiben az immunrendszer nem tudja leküzdeni és eltávolítani azt, fontos, hogy a kezelést a lehető leghamarabb megkezdjék. A legtöbb meningococcus-betegségben szenvedő ember kórházba kerül, és antibiotikumokkal kezelik. Nagyon fontos, hogy a páciens befejezze az antibiotikumok szedését, még akkor is, ha jobban érzi magát (hacsak az orvosa másként nem rendelkezik). A fertőzés súlyosságától függően más kezelésekre is szükség lehet. Ilyenek lehetnek például a légzéstámogatás, az alacsony vérnyomás kezelésére szolgáló gyógyszerek és a különböző testrészek bőrének sebkezelése.
Az emberek 5-25%-a hordozza a N. meningitidis baktériumot az orr és a torok hátsó részén anélkül, hogy bármilyen betegséget vagy tünetet mutatna. Amennyiben az immunrendszer nem tudja leküzdeni és eltávolítani azt, fontos, hogy a kezelést a lehető leghamarabb megkezdjék. A legtöbb meningococcus-betegségben szenvedő ember kórházba kerül, és antibiotikumokkal kezelik. Nagyon fontos, hogy a páciens befejezze az antibiotikumok szedését, még akkor is, ha jobban érzi magát (hacsak az orvosa másként nem rendelkezik). A fertőzés súlyosságától függően más kezelésekre is szükség lehet. Ilyenek lehetnek például a légzéstámogatás, az alacsony vérnyomás kezelésére szolgáló gyógyszerek és a különböző testrészek bőrének sebkezelése.
A mesterséges intelligencia szerint a sebkezelés és a meningococcus kapcsolata közvetlenül a baktérium fertőzési módjával és az érintett személyekkel való kapcsolattal áll összefüggésben. Mivel a meningococcus a légzőrendszeren vagy a közvetlen érintkezés útján terjedhet, sebek esetén a fertőzés veszélye függ a seb típusától, mélységétől és helyétől. A meningococcus egy főként cseppfertőzéssel terjedő betegség, amely elsősorban a légzőrendszeren keresztül terjed, például köhögés vagy tüsszentés során. Azonban olyan esetekben, amikor egy fertőzött személy vérrel vagy más testnedvekkel érintkezik egy seben keresztül, a meningococcus potenciálisan átvihető lehet.
A sebek kezelése során fontos az alapvető higiéniai gyakorlatok betartása, például a seb tisztán és szárazon tartása, a fertőtlenítés, valamint a megfelelő sebfedés alkalmazása. Ezek a gyakorlatok nem csak a meningococcus, hanem más kórokozók ellen is védelmet nyújthatnak.
Vonatkozó tanulmányok
A meningococcus fertőzésnek a bőrön látható megjelenéseiről még 1974-ben írtak egy cikket Warren H. Toews és James W. Bass (Honolulu, USA). A vizsgálatukban szereplő 151 fertőzött 14%-ának nem volt bőrelváltozása, 75%-ának generalizált makulopapuláris vagy petechiális, 11%-ának pedig perifériásan elhelyezkedő purpurás vagy ecchymotikus elváltozása volt. Azoknál a betegeknél, akiknek nem volt bőrelváltozása, vagy akiknek generalizált makula- vagy petechiális léziója volt, gyakrabban fordult elő meningitis, viszont kevesebb volt a fulmináns fertőzés. A sokk és a véralvadási faktor hiánya és/vagy a vérzéses diathesis (DIC) ritka volt ezeknél a betegeknél, és a mortalitás is alacsony volt (3%). A perifériás purpurás vagy ekchimotikus bőrelváltozásokban szenvedő betegeknél nagy gyakorisággal fordult elő fulmináns fertőzés, csekély vagy semmilyen meningealis érintettséggel. A legtöbb esetben sokk, DIC vagy mindkettő volt jelen, és a halálozás magas volt (44%). A meningococcus fertőzésben előforduló bőrelváltozások jelenléte, típusa és elhelyezkedése tehát a prognózis azonnali indikátoraként használható.
1999-ben jelent meg S. Thomas, J. Humphries és M. Fear-Price (Bridgend, Egyesült Királyság) esettanulmánya a nedves sebkezelés szerepéről a meningococcus okozta bőrelváltozások menedzsmentjében. Tanulmányuk azt sugallja, hogy az általuk alkalmazott megközelítés jelentős előnyökkel jár a további károsodások korlátozása, az automatikus sebfertőtlenítés megkönnyítése és a kozmetikailag is elfogadható gyógyulás elősegítése szempontjából. Ha a területek túl nagynak minősülnek ahhoz, hogy másodlagos szándékkal gyógyuljanak, a kötszerek segítenek a sebágy tisztításában a bőrátültetés előtt. Ha a hidrogéleket a leírt módon választják ki és használják, akkor átlátszó jellegük lehetővé teszi a sebterület folyamatos megfigyelését is. A modern kötszereknek további előnye, hogy azonnal alkalmazhatóak, amikor az elváltozást először észlelik, és nem zavarják a beteg kezelésének semmilyen más aspektusát, illetve nem vonják el a figyelmet a kezelés más, sürgősebb szempontjairól.
2012-ben mutatták be Tariq A. Khemees (Columbus, USA) és munkatársai egy 55 éves heteroszexuális férfi esetét, aki urethritisre és Fournier-gangrénára utaló tünetekkel jelentkezett a sürgősségi osztályon. A vizsgálatok koaguláz-negatív Staphylococcust és intracelluláris Gram-negatív diplococcust mutattak ki. A betegnek három különböző sebészeti beavatkozásra volt szüksége a kiterjedt nekrotizáló fertőzés megfékezéséhez. A steril sebgyógyulás megfelelő antibiotikumokkal történő dokumentálását követően négy helyreállító műtétre is szükség volt a keletkezett sebdefektusok kezeléséhez. Ez volt az első szakirodalmi beszámoló a N. meningitidisről mint a Fournier-gangréna kórokozójáról.
Az International Wound Journal 2013-ban publikálta Zeeshan Ahmad (Warwickshire, Egyesült Királyság) és munkatársai cikkét a dermális és epidermális szöveti nekrózissal járó, elsőként Guelliot által 1884-ben leírt meningococcus purpura fulminans (MPF) két esetéről. Megmutatták, hogy a betegség lágyszöveti megnyilvánulásai sikeresen kezelhetők konzervatív megközelítéssel, amely – szerintük – a megfelelő választás a natív szövetek maximális megőrzésére. Ezeknek a betegeknek a rehabilitációja hosszadalmas, és számos orvosi szakterület bevonását igényli a funkcionális kimenetel optimalizálása és a társadalomba való visszailleszkedés érdekében.
2014-es Xiaoyun Ren és Joanna K. MacKichan (Új-Zéland) közleménye arról, hogy a N. meningitidis izolátumok a IV-es típusú pilustól független módon gátolják a sebek gyógyulását a légúti hámsejtekben.
2014-es Xiaoyun Ren és Joanna K. MacKichan (Új-Zéland) közleménye arról, hogy a N. meningitidis izolátumok a IV-es típusú pilustól független módon gátolják a sebek gyógyulását a légúti hámsejtekben.
2015-ben Nikunj Mahida (Nottingham, Egyesült Királyság) és munkatársai egy halálos kimenetelű N. meningitidis szeptikémia és szívburokgyulladás kialakulásához vezető emberi harapás esetét mutatták be. A 43 éves nőbeteg vizsgálata során a bal mellen erythemás, fertőzött sebet találtak. Legjobb tudomásuk szerint ez volt az első olyan eset, amikor a N. meningitidis okozta cellulitisz emberi harapásból és az azt követő vérmérgezésből ered. Kiemelték továbbá a vértenyészet vételének fontosságát a szeptikémiás betegekben, és bemutatták a pericarditist, mint a meningococcus septicaemia ritka, de jelentős szövődményét.
2016-ban Jemell Geraghty egy fiatal beteg a közösségi és a járóbeteg-gyermekgyógyászati teamekkel közösen végzett sebkezelésének topikális kezelési módját mutatta be. Gyakorlati tippeket ismertetett a gyermekek összetett sebeinek kezelésére, hogy bemutassa, hogy az ilyen eseteket az ápolócsapatok hatásosan kezelhetik nyugodt otthoni környezetben és járóbeteg-ellátásban, megelőzve a visszafogadást és támogatva a gyermek és a szülők érzelmi felépülését. A kezelés sikere és a gyermek mindennapi életbe és iskolába való visszailleszkedése a szülők és a gyermek, valamint a szöveti életképességgel foglalkozó, gyermekgyógyászati és közösségi ápolói csoportok közös munkájának és együttműködésének volt köszönhető.
Összegzésképpen: a meningococcus-fertőzés nem elsősorban a sebek miatt jelentkezik, a megfelelő sebkezelés és általános higiéniai gyakorlatok betartása azonban fontos szerepet játszhat a fertőzés megelőzésében és kezelésében. Az egészségügyi szakembereknek és a lakosságnak egyaránt fontos ismernie ezt a kapcsolatot, hogy megfelelő lépéseket tehessenek a fertőzés megelőzése érdekében.

Meningococcus and wound healing
The US health authorities have alerted doctors to a growing number of cases of a rare meningococcal infection affecting middle-aged adults in the country, which has a higher than usual mortality rate, CNN' s Penzcentrum.hu reported on April 2. The infection, caused by the bacterium Neisseria meningitidis, can cause meningitis (inflammation of the brain and spinal cord) and sepsis. Typical symptoms include fever, headache, stiff neck, sensitivity to light and nausea. However, many recent cases differ from these symptoms, for example, two-thirds of them had a bloodstream infection (fever, chills, dark purple rash). Whether there is a link between the bacteria or meningococcus and wound care is the question I am trying to answer in this blog post.
Az illusztrációk forrása a Thebluediamondgallery.com és a Flickr.com.
Figyelem! Az eredeti poszt megjelenése után a blogbejegyzéseink csak igen ritkán frissülnek. Mivel az orvostudomány és az egészségipar folyamatosan fejlődik, egyes megállapítások már idejüket múlhatták, ezért feltétlenül figyelje a közzététel időpontját, és – ami még fontosabb – keresse a minél frissebb információkat!
Megosztás:
| Önt is várjuk a Magyar Sebkezelő Társaság tagjai közé! |
Ehhez:
Várjuk online jelentkezését! vagy kérjük, |



Kérjük, szóljon hozzá a cikkhez!